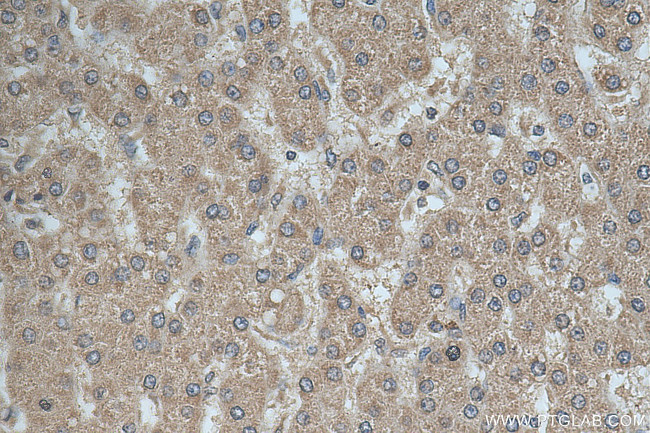
GALNT10 Antibody in Immunohistochemistry (Paraffin) (IHC (P))

Search
Proteintech
GALNT10 Polyclonal Antibody
{{$productOrderCtrl.translations['antibody.pdp.commerceCard.promotion.promotions']}}
{{$productOrderCtrl.translations['antibody.pdp.commerceCard.promotion.viewpromo']}}
{{$productOrderCtrl.translations['antibody.pdp.commerceCard.promotion.promocode']}}: {{promo.promoCode}} {{promo.promoTitle}} {{promo.promoDescription}}. {{$productOrderCtrl.translations['antibody.pdp.commerceCard.promotion.learnmore']}}
产品信息
20822-1-AP
种属反应
宿主/亚型
分类
类型
抗原
偶联物
形式
浓度
规格
纯化类型
保存液
内含物
保存条件
运输条件
产品详细信息
Immunogen sequence: EYAEYIYQRR PEYRHLSAGD VAVQKKLRSS LNCKSFKWFM TKIAWDLPKF YPPVEPPAAA WGEIRNVGTG LCADTKHGAL GSPLRLEGCV RGRGEAAWNN MQVFTFTWRE DIRPGDPQHT KKFCFDAISH TSPVTLYDCH SMKGNQLWKY RKDKTLYHPV SGSCMDCSES DHRIFMNTCN PSSLTQQWLF EHTNSTVLEK FNRN
靶标信息
GALNT10 is responsible for encoding a GalNAc polypeptide N-acetylgalactosaminyltransferase enzyme, which plays a crucial role in the synthesis of mucin-type oligosaccharides. The enzyme transfers GalNAc from UDP-GalNAc to either serine or threonine residues of polypeptide acceptors. It has been observed that the protein encoded by this gene may exhibit higher catalytic activity towards glycosylated peptides as compared to non-glycosylated peptides.
仅用于科研。不用于诊断过程。未经明确授权不得转售。
篇参考文献 (0)
生物信息学
蛋白别名: GalNAc transferase 10; GalNAc-T10; Polypeptide GalNAc transferase 10; Polypeptide N-acetylgalactosaminyltransferase 10; PP PPGANTASE10; pp-GaNTase 10; Protein-UDP acetylgalactosaminyltransferase 10; UDP-GalNAc:polypeptide N-acetylgalactosaminyltransferase 10; UDP-N-acetyl-alpha-D-galactosamine: polypeptide N-acetylgalactosaminyltransferase 9; UDP-N-acetyl-alpha-D-galactosamine:polypeptide N-acetylgalactosaminyltransferase 10 (GalNAc-T10); UDP-N-acetyl-alpha-D-galactosamine:polypeptide N-acetylgalactosaminyltransferase 9; unnamed protein product
基因别名: AU018154; C330012K04Rik; GalNAc-T10; GalNAc-T9; GALNACT10; GALNT10; Galnt9; PPGALNACT10; ppGaNTase; PPGANTASE10
UniProt ID: (Human) Q86SR1, (Mouse) Q6P9S7
Entrez Gene ID: (Human) 55568, (Mouse) 171212